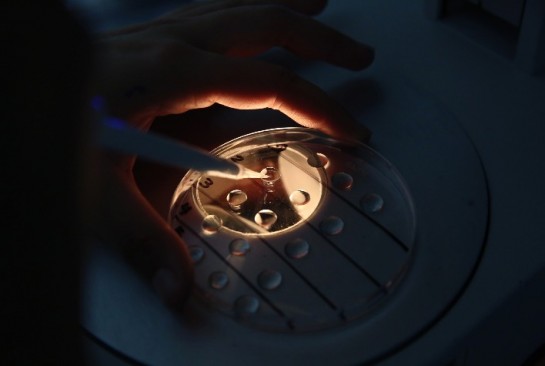
...

Notícias
-
16/06/2021 - Análise de Mercado
Agricultura irrigada é estratégica para produção de alimentos
Este foi um dos temas discutidos no evento “Irrigar é Alimentar”
-
16/06/2021 - Saúde Animal
Projeto aumenta acesso de pequenos produtores à tecnologia de embriões
Iniciativa visa à ampliação do acesso a tecnologias de melhoramento genético, potencializando aumentos da rentabilidade das pequenas e médias fazendas
-
16/06/2021 - Avicultura
Carne de frango in natura perde duas posições na pauta cambial brasileira
Mesmo tendo fechado os cinco primeiros meses de 2021 com incremento de quase 3% na receita cambial, a carne de frango in natura perdeu duas posições na pauta exportadora brasileira – tanto em relação ao mesmo período de 2020 quanto ao acumulado no primeiro quadrimestre deste ano
-
16/06/2021 - Bovinos de Corte
Megaleilão CFM oferta os 500 melhores touros Nelore CEIP nascidos em 2019
O 23º Megaleilão Nelore CFM será realizado, em versão virtual, no dia 5 de agosto. A CFM colocará à venda os 500 melhores touros Nelore CEIP nascidos em 2019.
-
16/06/2021 - Bovinos de Corte
Altas nas cotações no mercado do boi gordo
Segundo levantamento da Scot Consultoria, o boi, vaca e a novilha gordos foram negociados, respectivamente, em R$317,00/@, R$294,00/@, e R$310,00/@, preços brutos e a prazo
-
16/06/2021 - Governo
Conab avança no aprimoramento da produção de informações para o agro
No ano passado foram 79 milhões de hectares monitorados por 80 técnicos em campo e remotamente – a partir do uso de imagens de satélites, dentre outras ferramentas – permitindo a intensificação do mapeamento das culturas agrícolas.
-
16/06/2021 - Análise de Mercado
MERCADO DE TRABALHO AGRO: Geração de emprego no campo limita queda de população ocupada no agronegócio como um todo
O bom desempenho da agricultura no primeiro trimestre de 2021 elevou o número da população ocupada no segmento primário (“dentro da porteira”) frente ao mesmo período de 2020
-
16/06/2021 - Análise de Mercado
Diesel nos postos fica perto da estabilidade no início de junho; gasolina sobe
Segundo o índice de preços da Ticket Log, marca de gestão de frotas e soluções de mobilidade da Edenred Brasil, o diesel comum atingiu média de 4,729 reais por litro no início deste mês, alta de 0,64% ante o fechamento de maio
-
16/06/2021 - Avicultura
Frango vivo: nova alta reaproxima (mas não iguala) preços de Minas e de São Pau
Ontem (15), o frango vivo comercializado no mercado mineiro obteve o sétimo reajuste de preços do mês
-
16/06/2021 - Suíno
Suínos: mercado registra fortes altas nos preços
Os preços no mercado de suínos subiram em todas as modalidades nesta terça-feira (15)
-
16/06/2021 - Bovinos de Corte
Arroba elevada deve garantir lucro na pecuária em 2021 mesmo com alta de grãos, diz Athenagro
Segundo levantamento, os custos de produção da pecuária de corte aumentaram na ordem de 10% a 20% nos pacotes de tecnologias mais baixas e cerca de 30% nos sistemas mais produtivos
-
16/06/2021 - Análise de Mercado
Para FAO, produção mundial de carne de frango cresce 1,3% em 2021; a do Brasil, perto de 2%
Os 10 maiores produtores mundiais, mostra que EUA e China se encontram praticamente empatados na primeira posição, respondendo, cada um, por cerca de 17% do total mundial previsto